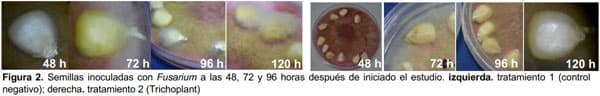

Protección de semillas de maíz contra el ataque de Fusarium moniliforme, Aspergillus flavus, Sclerotium sp., y Rhizoctonia solani
Publicado: 30 de abril de 2020
Fuente: Eliana Andrea Rincón, Jefe de laboratorio Sanoplant. Boletín Informativo Sanoplant No.2/2020
Con el objetivo de evaluar la eficacia de un fungicida comercial (Trichoplant - fungicida producido con varias cepas patógenas naturales y selectivas de Trichoderma harzianum, T. lignorum, T. viridae, Koningii) en el control del complejo fungoso Fusarium moniliforme, Aspergillus flavus, Sclerotium sp. y Rhizoctonia solani en semillas de maíz, bajo condiciones de laboratorio, los tratamientos control negativo (tratamiento 1) y el Producto comercial en dosis de 1 g/L (tratamiento 2) se diluyeron en agua destilada estéril y se aplicaron a semillas llevadas a bolsas ziploc, a razón de 15 cc de producto/kg de semilla. Las semillas tratadas se agitaron fuertemente para la homogenización del producto y se ubicaron sobre colonias puras del microorganismo patógeno crecido en cajas de Petri con medio de cultivo PDA.

Por cada tratamiento y hongo se tuvieron 4 repeticiones para un total de 40 unidades de observación. A las 48, 72, 96 y 120 horas después de iniciado el estudio, se determinaron el número de semillas con presencia del hongo y el número de semillas germinadas; a las 120 horas se evaluó la fitotoxicidad en términos de desarrollo de los epicótilos.
RESULTADOS
Se encontraron diferencias estadísticas significativas entre los tratamientos al evaluar el número de semillas germinadas, siendo el producto comercial el tratamiento que presentó la mayor media, de acuerdo a la prueba de Tukey al nivel del 5% (Tabla 1). En cuanto a las semillas con hongo, de acuerdo a la prueba de Tukey (5%), las diferencias estuvieron a favor del tratamiento 2 (Trichoplant) con una media de 4,86 semillas con hongo, en comparación del tratamiento 1 (control) cuya media fue de 9,88.


A diferencia del tratamiento control y como puede observarse en las siguientes Figuras, las semillas tratadas con Trichoplant presentaron menor crecimiento micelial, entre el cero y el 25% sobre la superficie total de la semilla. Al final de la evaluación se puede observar cómo Trichoderma spp., principios activos de Trichoplant, parasitan el microorganismo protegiendo la semilla.




CONCLUSIONES
- El fungicida comercial producido con varias cepas patógenas naturales y selectivas de Trichoderma harzianum, T. lignorum, T. viridae, Koningii favoreció la germinación de las semillas de maíz.
- Los microorganismos evaluados fueron patogénicos, presentándose en el testigo absoluto en el 98% de las semillas.
- En el tratamiento con el producto comercial, hubo la menor cantidad de semillas con hongo, lo que demuestra la eficacia de sus principios activos como antagonistas de microorganismos fitopatógenos.
- Las semillas tratadas con el producto presentaron menos severidad de los microorganismos que lograron parasitarlas, en comparación con el testigo absoluto.
- Trichoplant parasitó los microorganismos fitopatógenos que lograron crecer sobre las semillas del tratamiento, lo que demuestra que el producto comercial además de evitar el parasitismo, controla los patógenos de las semillas ya parasitadas.
Temas relacionados:
Recomendar
Comentar
Compartir
Sanoplant
21 de noviembre de 2020
Muy buenas tardes Ing German Colmenares, gracias por escribir, si los hemos realizados y la verdad han funcionado muy bien con excelente resultados de control y esta mezcla a demostrado efectos complementarios que funciona no solo para protección de granos sino para el control de Enfermedades con la mayoría de los sistemas de producción.
Consultar nuestra web Side: www.sanoplant.com.co
Celular 3128665646
Recomendar
Responder
19 de noviembre de 2020
Buenas tardes, interesante este trabajo, se han hecho trabajos de investigación con aplicación de Trichodrmas h. y Basillus subtilis???? a mi esa combinación me ha dado excelentes resultados en maíz y frijol, en suelos contaminados.
Recomendar
Responder
15 de noviembre de 2020
Cuando el agricultor hace uso de estos productos comerciales es porque el suelo de la finca del agricultor NO ESTA EN EQUILIBRIO MICROBIOLOGICO. En vez de hacer propagandas para la adquisición de productos que solo duran momentos muy pequeños en el cultivo se debería incentivar el uso de aplicaciones al suelo de microorganismos y la materia orgánica. OJO: Utilizar COMPLEJOS O COCTELES DE MICROROGANISMOS "NO microorganismos específicos".
El agricultor piensa en que aplicando materia orgánica (estiércol o mierdas) va a solucionar sus problemas, sien embargo, mucha de esta materia orgánica tiene un porcentaje reducido de microorganismos, se debe entonces incentivar a la reproducción microbiana.
Sugiero entren a la web www.lamierdadevaca.com y dejen de comprar productos comerciales que cuestan mucho y hacen muy poco.
Recomendar
Responder

¿Quieres comentar sobre otro tema? Crea una nueva publicación para dialogar con expertos de la comunidad.